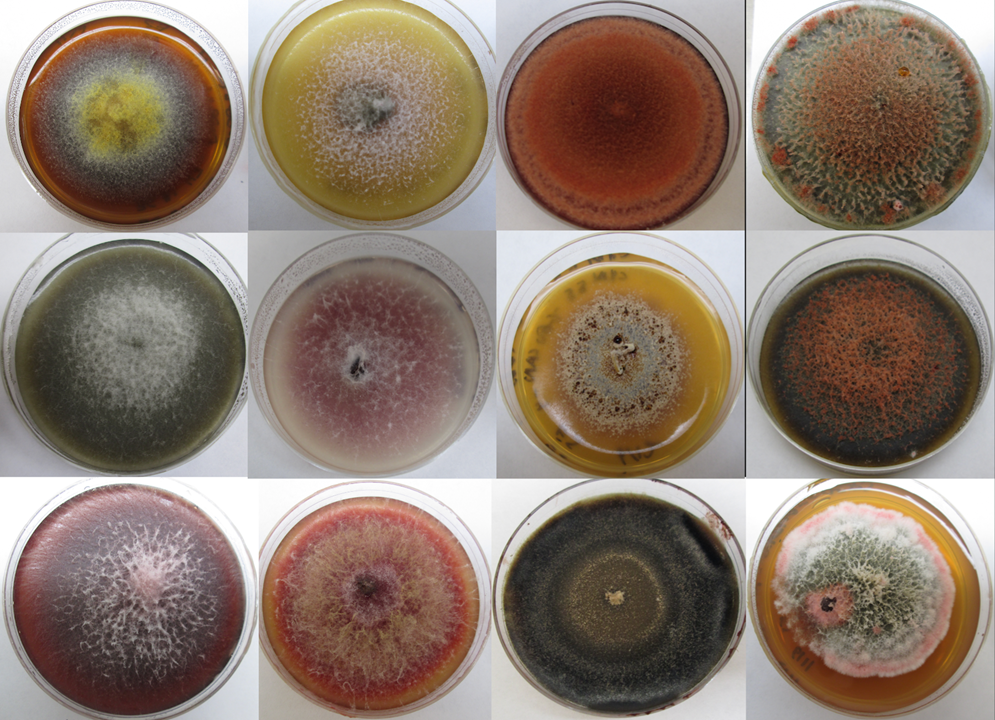
A selection of Petri dishes of different colors.; Disease in a Rapidly Changing World: Lessons from Seeds and their Pathogens

Biology Program Presents
Disease in a Rapidly Changing World: Lessons from Seeds and their Pathogens
Friday, April 18, 2025
Reem-Kayden Center Laszlo Z. Bito '60 Auditorium
12:00 pm EDT/GMT-4
A talk by Cathy Collins of the Biology Program.12:00 pm EDT/GMT-4
For more information, call 845-758-6822, or e-mail [email protected].
Time: 12:00 pm EDT/GMT-4
Location: Reem-Kayden Center Laszlo Z. Bito '60 Auditorium